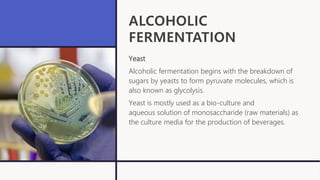
ALCOHOLIC
FERMENTATION
Yeast
Alcoholic fermentation begins with the breakdown of
sugars by yeasts to form pyruvate molecules, which is
also known as glycolysis.
Yeast is mostly used as a bio-culture and
aqueous solution of monosaccharide (raw materials) as
the culture media for the production of beverages.

The document discusses industrial biotechnology's role in beverage production, emphasizing advancements like fermentation techniques, starter cultures, and recombinant enzymes for enhancing product quality and safety. It categorizes beverages into alcoholic and non-alcoholic types, detailing production methods such as solid state and submerged fermentation. The application of modern biotechnology is noted to improve traditional processes, ensuring better nutritional and flavor profiles in various beverages.